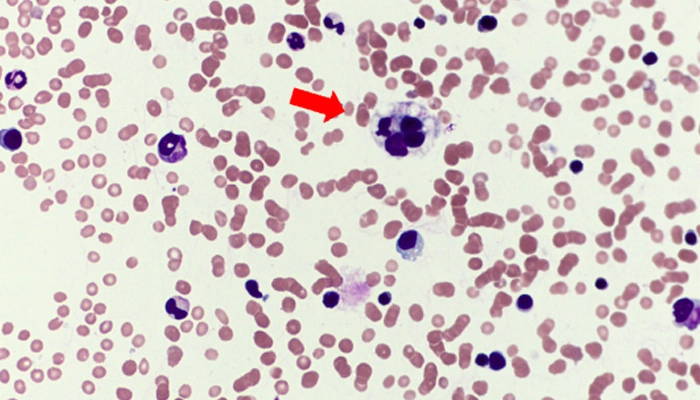

Hội Chứng Thực Bào Máu Là Gì? Nguyên Nhân, Triệu Chứng Và Cách Điều Trị
- 1. Hội chứng thực bào máu là gì?
- 2. Nguyên nhân gây hội chứng thực bào máu
- 3. Triệu chứng của hội chứng thực bào máu
- 4. Chẩn đoán hội chứng thực bào máu
- 5. Cách điều trị hội chứng thực bào máu
- 6. Tiên lượng và biến chứng
- 7. Phòng ngừa hội chứng thực bào máu
- 8. Khi nào cần gặp bác sĩ?
- 9. Câu hỏi thường gặp về hội chứng thực bào máu
- Kết luận
Hội chứng thực bào máu (Hemophagocytic Lymphohistiocytosis – viết tắt là HLH) là một rối loạn miễn dịch nghiêm trọng, hiếm gặp nhưng có thể đe dọa tính mạng nếu không được chẩn đoán và điều trị kịp thời. Bệnh đặc trưng bởi sự hoạt hóa quá mức của hệ miễn dịch, khiến các tế bào miễn dịch tấn công chính các tế bào máu trong cơ thể.
Dù xuất hiện chủ yếu ở trẻ nhỏ, HLH cũng có thể xảy ra ở người trưởng thành do các yếu tố như nhiễm virus, ung thư hoặc rối loạn tự miễn. Việc nhận biết sớm các triệu chứng như sốt kéo dài, gan lách to, thiếu máu, giảm bạch cầu và tiểu cầu đóng vai trò quan trọng trong tiên lượng bệnh.
Bài viết này sẽ giúp bạn hiểu rõ hội chứng thực bào máu là gì, nguyên nhân gây bệnh, các dấu hiệu đặc trưng, cũng như hướng điều trị hiện nay được áp dụng tại Việt Nam và trên thế giới.
Hình ảnh đại thực bào tấn công và ăn tế bào máu
1. Hội chứng thực bào máu là gì?
Hội chứng thực bào máu (HLH) là tình trạng hệ miễn dịch bị kích hoạt quá mức, dẫn đến việc đại thực bào và tế bào lympho T tấn công và “ăn” chính các tế bào máu của cơ thể, bao gồm bạch cầu, hồng cầu và tiểu cầu.
Cơ chế này khiến các cơ quan như gan, lách, tủy xương và hệ thần kinh trung ương bị tổn thương nghiêm trọng, dẫn đến suy đa cơ quan nếu không được điều trị kịp thời.
Phân loại hội chứng thực bào máu:
Hội chứng thực bào máu được chia thành hai nhóm chính:
-
HLH nguyên phát (di truyền): Thường xuất hiện ở trẻ nhỏ, do đột biến gen làm suy giảm khả năng điều hòa miễn dịch.
-
HLH thứ phát (mắc phải): Xuất hiện ở mọi lứa tuổi, thường liên quan đến các bệnh lý khác như:
-
Nhiễm virus (đặc biệt là EBV, CMV, HIV)
-
Ung thư (đặc biệt là u lympho)
-
Bệnh tự miễn (lupus, viêm khớp dạng thấp,...)
-
Sau ghép tạng hoặc điều trị thuốc ức chế miễn dịch.
-
2. Nguyên nhân gây hội chứng thực bào máu
2.1. HLH nguyên phát (do di truyền)
Dạng di truyền thường xảy ra ở trẻ sơ sinh hoặc trẻ nhỏ, liên quan đến các đột biến gen như:
-
PRF1, UNC13D, STX11, STXBP2, LYST, RAB27A,... Những đột biến này ảnh hưởng đến quá trình “giết tế bào nhiễm bệnh” của tế bào NK (Natural Killer) và lympho T, khiến hệ miễn dịch bị kích hoạt liên tục.
2.2. HLH thứ phát (do bệnh lý mắc phải)
Dạng mắc phải có thể được kích hoạt bởi nhiều yếu tố, bao gồm:
-
Nhiễm trùng virus: EBV (Epstein–Barr virus) là tác nhân phổ biến nhất.
-
Bệnh ác tính: U lympho tế bào T, bạch cầu, hoặc các bệnh ung thư máu khác.
-
Bệnh tự miễn: Lupus ban đỏ hệ thống, viêm khớp tự phát, Still ở người lớn,...
-
Thuốc và hóa chất: Một số thuốc điều trị ung thư hoặc ức chế miễn dịch có thể gây phản ứng HLH.
-
Ghép tủy hoặc ghép tạng: Có thể kích hoạt phản ứng miễn dịch quá mức.
.webp)
Cơ chế bệnh sinh của hội chứng thực bào máu
3. Triệu chứng của hội chứng thực bào máu
Triệu chứng của HLH thường không đặc hiệu và dễ nhầm với nhiễm trùng hoặc bệnh viêm nặng. Tuy nhiên, người bệnh thường có biểu hiện toàn thân và huyết học rõ rệt, bao gồm:
3.1. Triệu chứng lâm sàng
-
Sốt cao kéo dài: Hầu như luôn xuất hiện, không đáp ứng với kháng sinh.
-
Gan và lách to: Là dấu hiệu điển hình do sự tích tụ tế bào thực bào.
-
Phát ban, vàng da: Do rối loạn chức năng gan.
-
Rối loạn thần kinh: Co giật, rối loạn ý thức, liệt nhẹ.
-
Sụt cân, mệt mỏi, suy nhược.
3.2. Triệu chứng cận lâm sàng
Để chẩn đoán HLH, bác sĩ sẽ dựa vào tiêu chuẩn của Hiệp hội HLH (Histiocyte Society), bao gồm ít nhất 5/8 dấu hiệu sau:
| Tiêu chí | Mô tả chi tiết |
|---|---|
| 1. Sốt | Sốt cao dai dẳng ≥ 38,5°C |
| 2. Lách to | Gan lách to rõ, thường sờ thấy dưới bờ sườn |
| 3. Giảm ≥ 2 dòng tế bào máu | - Hồng cầu: Hb < 9 g/dL - Tiểu cầu < 100.000/mm³ - Bạch cầu trung tính < 1.000/mm³ |
| 4. Tăng triglycerid và/hoặc giảm fibrinogen | - Triglycerid ≥ 265 mg/dL (≥ 3 mmol/L) - Fibrinogen ≤ 150 mg/dL (≤ 1,5 g/L) |
| 5. Có bằng chứng thực bào trong mô | Thấy tế bào thực bào ăn hồng cầu, bạch cầu hoặc tiểu cầu trong tủy xương, gan, lách hoặc hạch lympho |
| 6. Hoạt độ tế bào NK giảm hoặc mất | Kiểm tra bằng xét nghiệm chức năng tế bào NK (natural killer cells) |
| 7. Ferritin huyết thanh tăng cao | Ferritin > 500 ng/mL (thường > 3.000–10.000 ng/mL trong HLH) |
| 8. Tăng hòa tan CD25 (sIL-2 receptor) | sCD25 > 2400 U/mL (phản ánh sự hoạt hóa quá mức của tế bào lympho T) |
4. Chẩn đoán hội chứng thực bào máu
Chẩn đoán hội chứng thực bào máu (HLH) thường khá phức tạp do triệu chứng dễ nhầm lẫn với các bệnh lý khác như nhiễm khuẩn huyết, lupus ban đỏ hệ thống hoặc ung thư máu.
Các phương pháp chẩn đoán chính bao gồm:
-
Xét nghiệm máu tổng quát: Ghi nhận giảm tế bào máu, tăng ferritin, men gan và rối loạn đông máu.
-
Sinh thiết tủy xương hoặc gan: Phát hiện hình ảnh tế bào thực bào “ăn” hồng cầu, bạch cầu hoặc tiểu cầu.
-
Xét nghiệm di truyền: Tìm đột biến gen liên quan đến HLH di truyền (primary HLH).
-
Xét nghiệm virus và bệnh tự miễn: Hỗ trợ xác định nguyên nhân khởi phát HLH thứ phát (secondary HLH).

Trong thực hành lâm sàng, sinh thiết tủy xương được xem là ‘tiêu chuẩn vàng’ để chẩn đoán xác định HLH, đặc biệt khi thấy rõ hình ảnh thực bào trong tủy
5. Cách điều trị hội chứng thực bào máu
Mục tiêu điều trị HLH là giảm phản ứng viêm quá mức và điều trị nguyên nhân khởi phát.
5.1. Điều trị cấp cứu
Khi bệnh nhân có dấu hiệu sốc, suy gan hoặc suy đa cơ quan, cần:
-
Điều trị hỗ trợ tích cực (truyền máu, hô hấp, lọc máu, dinh dưỡng).
-
Điều chỉnh rối loạn đông máu và điện giải.
5.2. Điều trị đặc hiệu
Phác đồ chuẩn hiện nay là HLH-94 hoặc HLH-2004, bao gồm:
-
Corticosteroid (Dexamethasone): Giảm viêm và ức chế miễn dịch.
-
Etoposide (VP-16): Ức chế hoạt động quá mức của tế bào lympho T.
-
Cyclosporin A: Ức chế miễn dịch chọn lọc.
-
Immunoglobulin tĩnh mạch (IVIG): Áp dụng cho trường hợp HLH do nhiễm virus.
-
Ghép tủy xương (HSCT): Là phương pháp duy nhất có thể chữa khỏi HLH di truyền hoặc tái phát nặng.
5.3. Điều trị nguyên nhân nền
-
Nếu do virus EBV, có thể dùng Rituximab.
-
Nếu do ung thư máu, cần phối hợp hóa trị.
-
Nếu do bệnh tự miễn, dùng Steroid liều cao + thuốc ức chế miễn dịch (Cyclophosphamide, Methotrexate).
6. Tiên lượng và biến chứng
Nếu được phát hiện sớm và điều trị đúng phác đồ, nhiều bệnh nhân có thể hồi phục hoàn toàn. Tuy nhiên, tiên lượng phụ thuộc vào:
-
Nguyên nhân gây HLH
-
Thời gian phát hiện và điều trị
-
Tình trạng tổn thương gan, thận, não
Tỷ lệ tử vong của HLH có thể lên đến 40–60%, đặc biệt ở những trường hợp nặng hoặc chậm chẩn đoán. Các biến chứng thường gặp gồm:
-
Suy gan, suy thận, suy tủy xương
-
Nhiễm trùng huyết
-
Tổn thương thần kinh vĩnh viễn

Hội chứng thực bào máu là bệnh lý nguy hiểm tính mạng nhưng có thể kiểm soát nếu được chẩn đoán sớm, điều trị tích cực và theo dõi lâu dài.
7. Phòng ngừa hội chứng thực bào máu
Không có biện pháp phòng ngừa đặc hiệu cho HLH di truyền, nhưng bạn có thể giảm nguy cơ mắc HLH thứ phát bằng cách:
-
Điều trị sớm các bệnh nhiễm trùng virus.
-
Theo dõi sức khỏe định kỳ nếu đang mắc bệnh tự miễn hoặc ung thư.
-
Tránh lạm dụng thuốc ức chế miễn dịch.
-
Tư vấn di truyền học nếu trong gia đình có tiền sử HLH.
8. Khi nào cần gặp bác sĩ?
Bạn nên đến cơ sở y tế ngay nếu có các dấu hiệu sau:
-
Sốt kéo dài >7 ngày không rõ nguyên nhân
-
Xuất hiện thiếu máu, bầm da, gan lách to
-
Cảm thấy mệt mỏi, sụt cân nhanh, vàng da
-
Có tiền sử bệnh tự miễn hoặc ung thư máu
Chẩn đoán sớm giúp tăng cơ hội sống còn và giảm nguy cơ tổn thương đa cơ quan.
9. Câu hỏi thường gặp về hội chứng thực bào máu
9.1. Hội chứng thực bào máu có lây không?
Không. HLH không phải bệnh truyền nhiễm. Tuy nhiên, nếu nguyên nhân do virus (như EBV), virus đó có thể lây qua nước bọt hoặc dịch tiết.
9.2. Hội chứng thực bào máu có chữa khỏi hoàn toàn được không?
HLH di truyền có thể chữa khỏi nếu được ghép tủy xương thành công. Với HLH thứ phát, việc điều trị sớm giúp nhiều bệnh nhân hồi phục hoàn toàn.
9.3. HLH có giống ung thư máu không?
Không hoàn toàn giống, nhưng HLH có thể xảy ra cùng với ung thư máu (như u lympho hoặc bạch cầu cấp), vì vậy cần chẩn đoán phân biệt.
9.4. Xét nghiệm ferritin cao có nghĩa là bị HLH không?
Không hẳn. Ferritin tăng cao chỉ là dấu hiệu gợi ý, cần kết hợp với nhiều tiêu chí khác để chẩn đoán HLH chính xác.
9.5. Trẻ nhỏ bị HLH có di truyền cho anh chị em không?
Có thể. Nếu HLH do đột biến gen, các thành viên khác trong gia đình nên được xét nghiệm di truyền để đánh giá nguy cơ.
Kết luận
Hội chứng thực bào máu (HLH) là một bệnh lý miễn dịch hiếm gặp nhưng cực kỳ nguy hiểm, có thể xảy ra ở cả trẻ em và người lớn. Việc hiểu rõ nguyên nhân, triệu chứng và phương pháp điều trị là chìa khóa giúp phát hiện sớm và xử trí hiệu quả.
Nếu bạn hoặc người thân có dấu hiệu nghi ngờ HLH, hãy đến bệnh viện chuyên khoa huyết học – miễn dịch để được chẩn đoán và điều trị kịp thời. Can thiệp sớm là yếu tố quan trọng nhất giúp cải thiện tiên lượng và bảo vệ tính mạng người bệnh.
Số lần xem: 104




